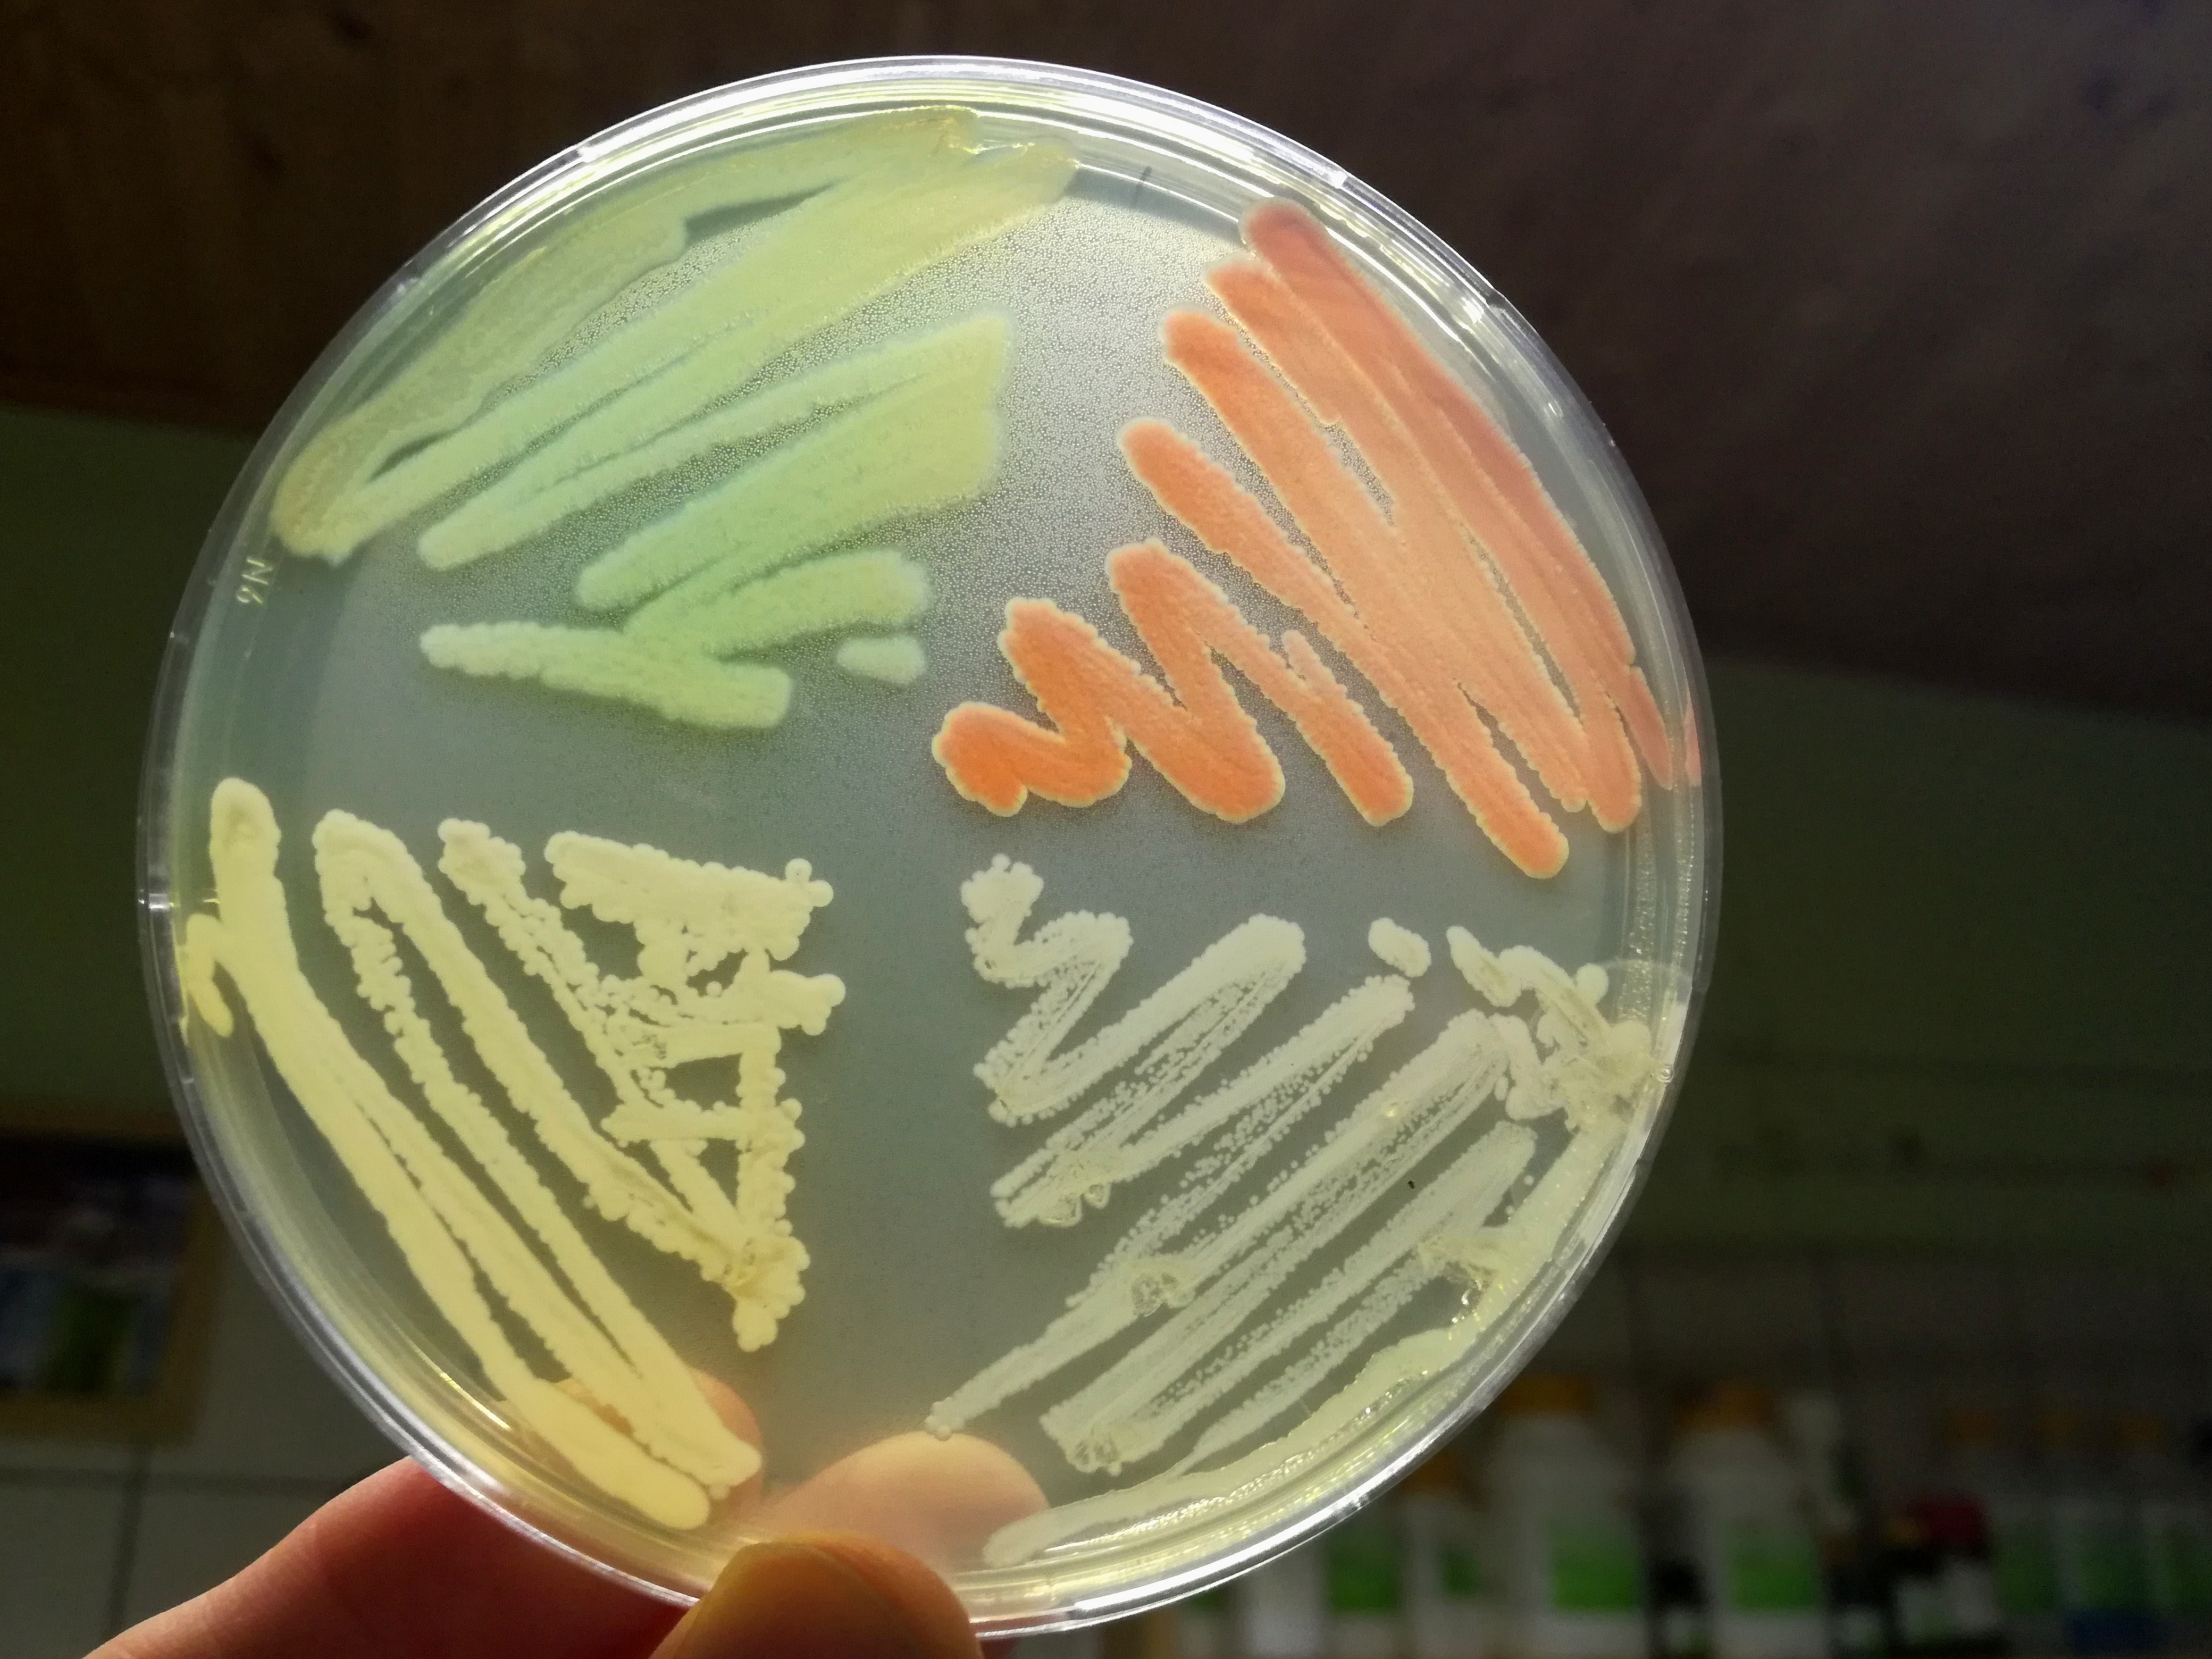
img_20180226_220029a.jpg

Media Manager
Namespaces
Choose namespace
Media Files
Files in danield

- 1446663465309p.jpg
- 270×480
- 2025-11-09 09:25
- 45.3 KB
- abschliessende_worte_vom_obmann.pdf
- 2025-11-09 09:25
- 101.3 KB

- daniel-derndorfer.jpg
- 2243×3052
- 2025-11-09 09:25
- 1.5 MB
- dd_da_-_biohazard.pdf
- 2025-11-09 09:25
- 1.1 MB

- dsc_0260a.jpg
- 1080×1241
- 2025-11-09 09:25
- 235.2 KB

- image113.png
- 2704×409
- 2025-11-09 09:25
- 1.2 MB

- image114.png
- 2670×363
- 2025-11-09 09:25
- 1.3 MB

- image117.png
- 2704×409
- 2025-11-09 09:25
- 1.6 MB

- image119.png
- 2704×409
- 2025-11-09 09:25
- 1.2 MB

- image120.png
- 2704×408
- 2025-11-09 09:25
- 1.4 MB

- img_20161207_105400a.gif
- 983×1126
- 2025-11-09 09:25
- 484.9 KB
- img_20180226_220029a.jpg
- 4160×3120
- 2025-11-09 09:25
- 3.3 MB

- logo.jpg
- 540×601
- 2025-11-09 09:25
- 24.3 KB
- phagenpraesentation-1.6.pdf
- 2025-11-09 09:25
- 2.8 MB

- potluck_s.jpg
- 1479×1705
- 2025-11-09 09:25
- 900 KB
- praesentation_derndorfer_poechlauer_biohacking_genome_editing.pdf
- 2025-11-09 09:25
- 1.2 MB

- wasserzeichen.png
- 2704×409
- 2025-11-09 09:25
- 155.6 KB

